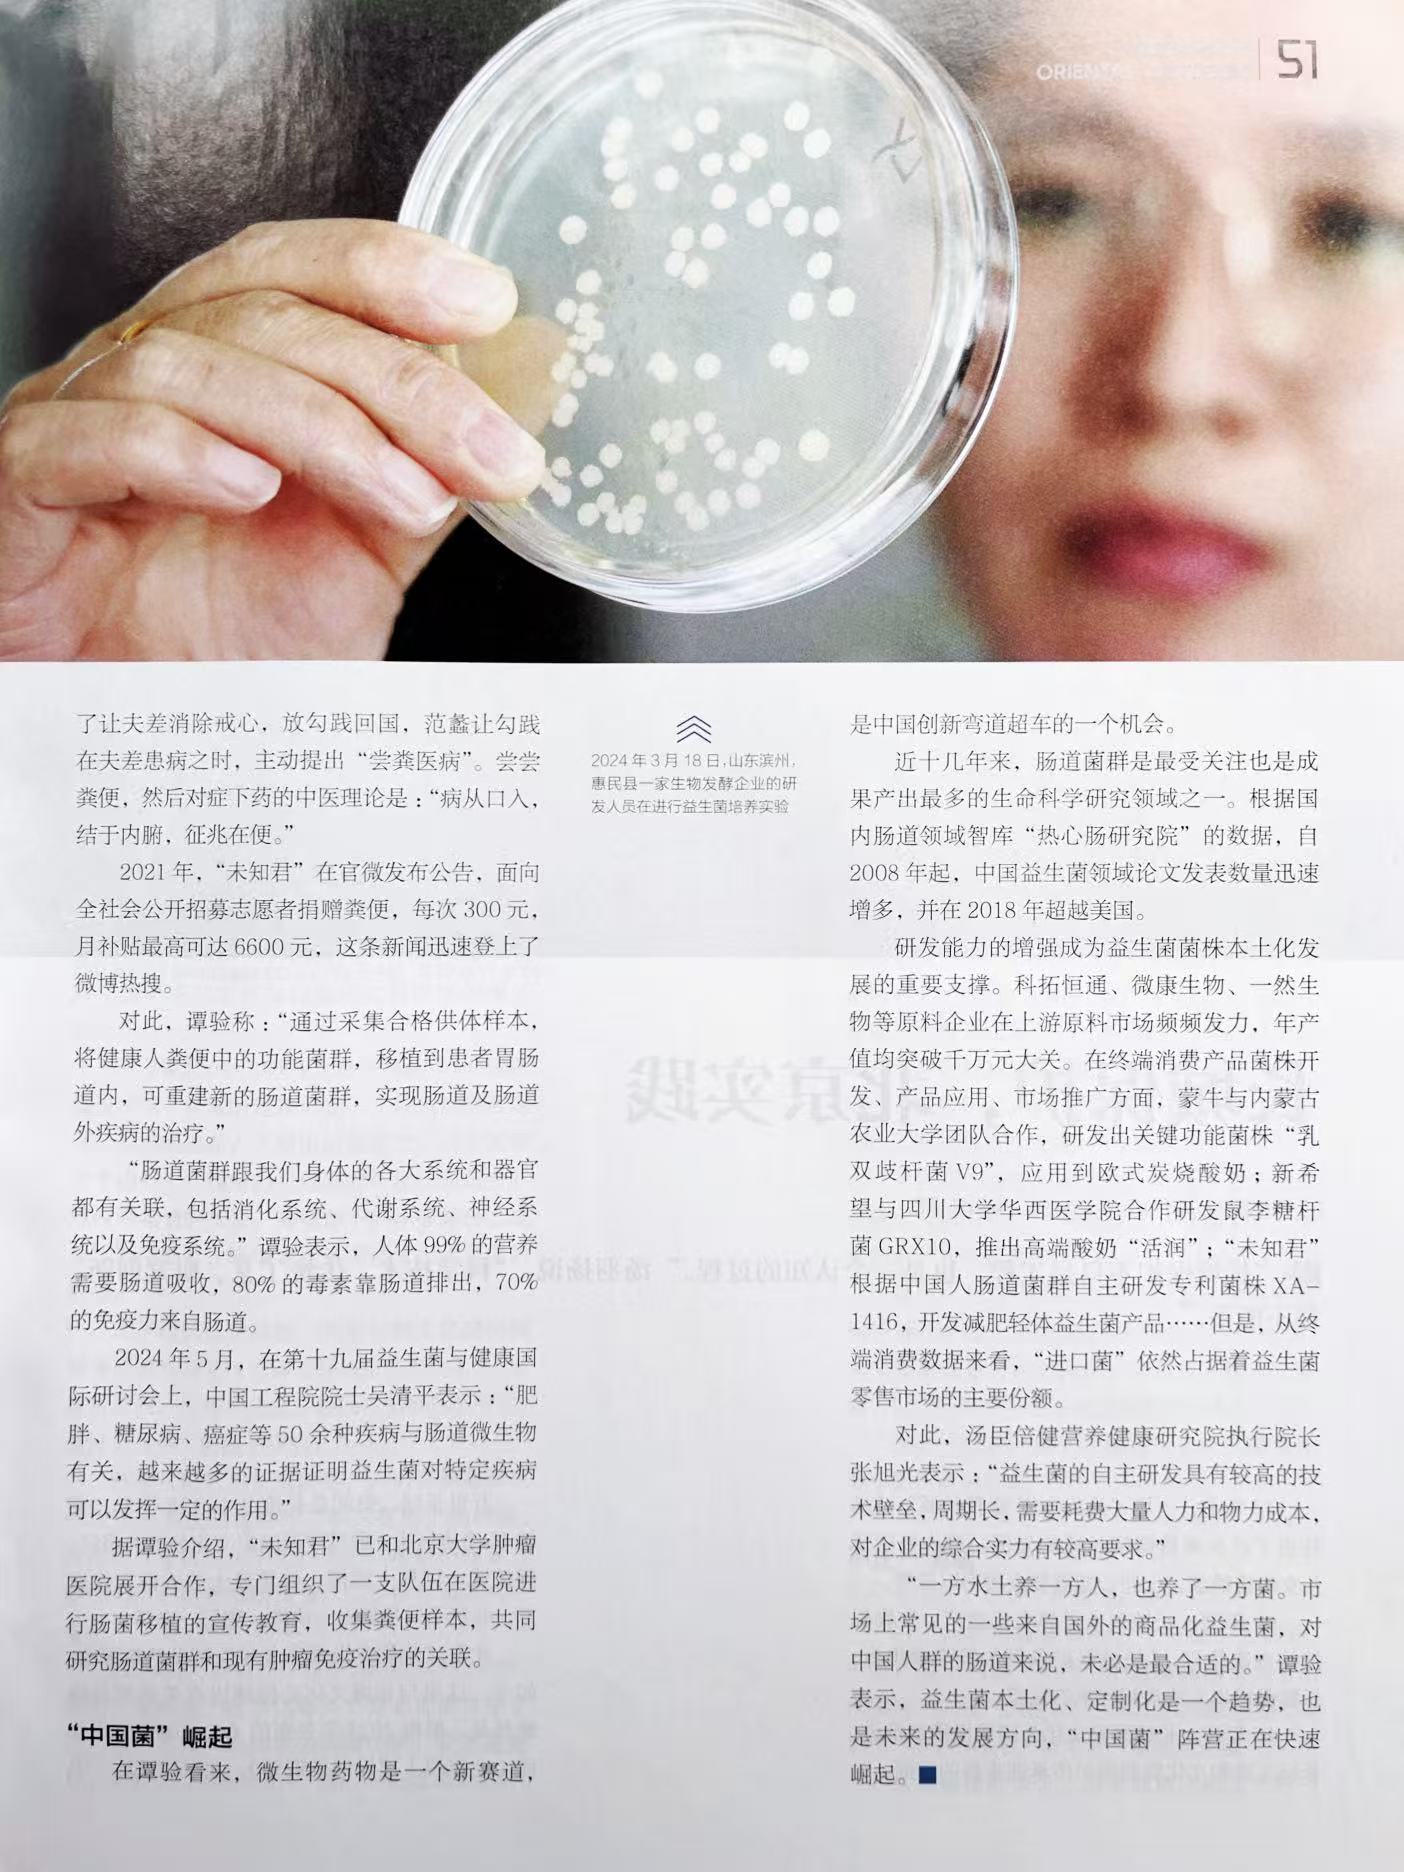

9月27日,第八届年度经济大会暨2025健康产业论坛在北京召开。大会聚焦经济领域热点议题,探讨产业升级、科技创新与高质量发展路径,为推动我国新质生产力培育和高质量发展建言献策。

中国关工委常务副主任、中共中央宣传部原副部长胡振民,中共中央对外联络部原副部长马文普,中国节能协会监事长房庆,中国人民大学教授、博士生导师王亚星等领导嘉宾出席此次会议。
未知君携科学减脂“中国菌”——唾液联合乳杆菌XA-1416在大会亮相。凭借完备的减脂减重机制研究、功能验证,以及卓越的人体数据,XA-1416菌株荣获2025年度AI人工智能卓越产品奖,未知君荣获2025年度AI融合健康创新企业奖。


XA-1416是未知君利用制药级的AI+BT技术平台发掘、出品的明星菌株之一,是从健康中国人群肠道中分离出的“中国菌”“原籍菌”;已正式获批国家发明专利。专利申报资料显示,该菌株可通过四大科学机制实现“智能减脂”。菌株可通过提升胆盐水解酶(BSH)活性,将结合型胆汁酸转化为游离形式,减少脂肪在肠道吸收效率,加速脂肪排出;可刺激肠道分泌GLP-1激素,延缓胃排空、增加饱腹感,同时安全调控血糖水平,无副作用;可降低“致胖菌”(如毛螺菌科等),降低厚壁菌门/拟杆菌门比值,恢复菌群健康比例;可减少脂肪细胞脂滴聚集,减少内脏脂肪和白色脂肪比重。

动物实验数据显示,该菌株显著抑制体重增长,降低血脂,尤其是降低低密度胆固醇(LDL-C)水平,减少内脏脂肪,改善肝损伤指标,并激活肠激素GLP-1。该菌株可实现减脂、维持肌肉量,还可以避免传统减肥方式导致的“代谢反弹”和体重复弹。在深圳市科技重大专项的支持下,未知君与中山大学公共卫生学院(深圳)合作,围绕XA-1416开展随机双盲安慰剂对照的RCT临床研究,验证XA-1416在人体中的减脂效果和机制。
从早期研发阶段开始,该菌株就已经“荣誉加身”——2024年,XA-1416在国家级媒体新华社与瞭望东方周刊的益生菌行业深度报道中,被誉为中国人源、功能创新的“中国菌”代表;该菌株及相关产品先后被评为2024年度深圳健康产业产品技术创新案例奖,以及2025未来医疗医药100强榜单最佳生物技术创新产品奖。
此次XA-1416闪耀2025年度经济大会,斩获两项大奖,再次验证了XA-1416的减脂“硬实力”,也体现了公众、行业期待利用肠菌减脂减重的呼声。2024年6月,国家卫健委联等16部门正式启动“体重管理年”三年专项行动,将解决肥胖问题上升为国家战略;未知君将持续借助AI+BT技术平台,用科学创新菌株在体重管理场景守护国人健康。
注:以上内容不涉及产品功效宣传,仅援引已公开的相关专利的申报资料,作为原料菌株科普介绍之用。
-End-